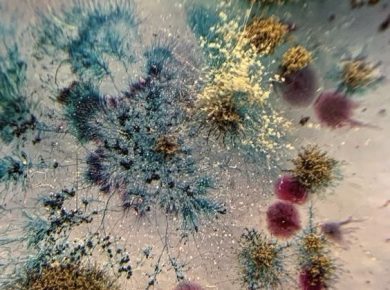

Observ, mai ales la unii tineri, rigiditatea în gândire și indisponibilitatea de a accepta că lumea are infinite nuanțe. Pentru a înțelege viața, este necesar să renunțăm la numeroasele reguli proprii şi să fim deschiși spre experiență. Oricâte cărți ai citi, oricâte cursuri ai face și școli ai absolvi, experiența directă te învață mult mai multe despre tine însuţi și despre lumea înconjurătoare.
Cărțile îți pot insufla niște idealuri, viața însă te învață în ce măsură ele pot fi trăite sau nu.
Cărțile îți prezintă modele sau antiexemple caracteriale și comportamentale, viața te pune în situații dificile de a alege între bine și rău, de a tolera disconfortul propriilor alegeri din care nu au rezultat lucrurile la care te-ai gândit inițial.
Cărțile îți prezintă scenarii din timpuri trecute sau actuale, în timp ce prezentul continuu al vieții cere o adaptare la resursele pe care le ai.
Cărțile oferă cunoștințe și repere istorice, culturale, etnografice, viața însă te așază într-un context pentru care de multe ori nu ești pregătit, nu ai toate datele problemelor și te adaptezi din mers, deseori greșești sau regreți lucruri pe care le-ai făcut.
Cărțile se citesc în interiorul confortabil al unei case, pe un fotoliu, cu o cană de ceai în mână, dar viața te surprinde în cele mai neașteptate moduri, uneori profund ironic, alteori amuzant.
Cărțile îți oferă un fir narativ coerent, au un început, o intrigă, un deznodământ, un final, în viață atunci când crezi că e deznodământul, de fapt, acesta maschează un nou început psihologic sau relațional.
Cărțile îți oferă o bogăție a limbajului și a exprimării, viața te face de multe ori să-ți pierzi cuvintele și să nu te poți exprima în fața complexității ei.
Cărțile explică concepte în mod clar, viața te învață regulile ei „din mers”, fără să-ți ofere un preambul.
Cărțile sunt importante pentru că, odată citite, ne îmbogățesc viziunea asupra lumii, viața este necesar să fie trăită, gustată, savurată, înțeleasă până în străfunduri, iar trăirea ei ne face să simțim că suntem mai aproape de a ne împlini menirea pe pământ.
Fără a minimaliza importanța cunoașterii, abordarea sănătoasă este o conjuncție între studiu și experiență, iar prezența uneia nu o exclude pe cealaltă.
Principiile sunt importante, dar trăirea vieții este și mai importantă, aşadar, spune „da” vieții, oricât de riscant ar fi în unele momente.
Am ajuns să cred că e bine să faci greșeli cât mai repede, să te maturizezi cât mai repede, ca apoi să-ți stabilești un traseu care să cuprindă cunoaşteri din experiență directă. Dacă tu ai crescut ca într-o seră, încă nu știi cum vei reacționa la asperitățile lumii din afara bulei tale.
Drumul cunoașterii este lung, iar mentalitatea potrivită îți este cel mai bun aliat.
Vindecarea de comoditate
La fel ca și în cazul vieții, care este necesar să fie experimentată pentru a putea fi înțeleasă la un alt nivel, și în cazul iubirii, oricât citești despre ea, ai nevoie să o experimentezi într-un mod matur.
Dacă în timpuri străvechi pericolele erau reprezentate de prădători, lipsa resurselor materiale, o medicină precară, astăzi sunt rezolvate aceste probleme la un nivel satisfăcător și, în mod neașteptat, o altă provocare se ivește pentru noi – comoditatea.
Am încercat să găsesc o descriere potrivită pentru acest cuvânt, iar dicționarul m-a salvat și de data aceasta: „tihnit, leneș, indolent, care nu vrea să facă eforturi, care nu vrea să iasă din obiceiurile lui, din ritmul lui tihnit, obișnuit de viață”.
Cum te vindeci de comoditate? Prin asumarea responsabilității, în primul rând. Mereu le spun prietenilor că mutatul de acasă te vindecă de comoditate, pentru că aceasta vine la pachet cu o enormă responsabilitate față de viața ta, inclusiv în chestiuni administrative, cum ar fi plătitul facturilor, al chiriei, cumpărături și în alte aspecte mai importante, precum jobul, facultatea, proiecte, colaborări, relații.
Ideea este că mereu apar provocări, mereu ai de făcut lucruri care țin în mod direct de tine și care sunt în responsabilitatea ta și nu prea ai de ales decât să-ți îndeplinești cu conștiinciozitate îndatoririle, fără să ții foarte mult cont de dispozițiile tale fluctuante, chiar dacă ți-ai dori să stai o zi pe balansoar cu cartea în mână, să urci pe munți sau să te uiți pe tavan.
Al doilea lucru care te vindecă de comoditate este înțelegerea iubirii mature.
Iubirea matură înseamnă preocupare activă pentru binele celuilalt (a nu se înțelege să fii vasalul toanelor lui). Înseamnă să fii aproape când are nevoie de tine, fie că este vorba de un ceai cald, o poveste de o jumătate de oră sau sprijin la o temă. Iubirea activă înseamnă că ajuţi, dacă o persoană are nevoie de tine; înseamnă să oferi un umăr celuilalt când suferă, chiar dacă și sufletul tău e zdrobit la rândul lui; înseamnă altruism, adică să îți amâni temporar dorințele sau dispozițiile și să fii alături de o persoană, atunci când prezența ta îi este necesară.
Iubirea te vindecă de comoditate definitiv, spun de regulă părinții copiilor, lași confortul și faci ce este necesar, când este necesar.
Cum aş descrie absența comodității? A fi treaz, prezent, conștient de nevoile celuilalt, conștient de tine pentru a le putea anticipa. Nu e greu să faci ceva pentru o persoană, nu e un efort substanțial să o ajuți, să o iubești și să o susții.
Una dintre lucrările iubirii în noi este aceasta: vindecarea de comoditate.
Vindecarea de comoditate te face proactiv social – iei uşor inițiativa de a ajuta acolo unde este nevoie, de a face un bine sau, pur şi simplu, de a oferi un zâmbet. Să dai din resursele tale și celorlalți pare ca și cum ai accesa o mentalitate a abundenței.
Găsești resurse în tine. Poți. Știi cum. Găsești o cale. Te implici total, iar aceasta pe termen lung îți crește calitatea vieții și a relațiilor.
Cred cu tărie că ne putem vindeca de comoditate și cu ajutorul voinței. Dacă decizi ca de mâine să fii mai atent la cel de lângă tine (nu la o lume întreagă, ci la cel lângă care te trezești dimineața sau cu care împarți casa, la familia ta extinsă), poți să te vindeci de comoditate.
Inclusiv calea vindecării emoționale singur sau în cuplu nu este o cale comodă sau simplă, presupune a simți durerea, pierderea, frângerea de a-ți vedea și asuma nedisimulat greșelile, puterea de a-ți simți imperfecțiunea și vulnerabilitatea. Nu am găsit căi ușoare spre vindecarea emoțională și restaurarea relațiilor.
Când ajungem la fundul prăpastiei și considerăm că nu mai e nici o șansă pentru noi, exact atunci simţim că parcă ne cresc aripi.
Probabil că cel mai jos punct al vieții noastre este cel de care avem nevoie pentru a renaște.
Probabil că ajungerea în colaps este unul dintre ingredientele reconstruirii, devii un alt om, cu o altă identitate, chiar dacă este necesar, în primă fază, să tolerezi vidul de după spulberarea unei identități cu care te-ai obișnuit, dar aceasta înseamnă evoluție.
*Articol publicat și în Ziarul Lumina.